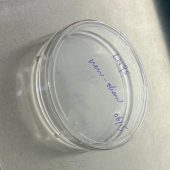
new-thaw cells

写在前面:作为该专题的第一篇,肯定得讲最重要的东西了——怎么养细胞🧫。要是细胞都养不活那后面的实验就都不用做了😂。。不同的细胞特性不一样,养的方式自然也不一样,不过大抵上是有个general procedure的,听我一一道来。
养细胞前 Before Culturing Cells
① Biosafety Cabinet (BSC, 生物安全柜)
所有关于cell culture的实验都必须在Biosafety Cabinet内进行。用之前要先穿好实验服🥼,戴好手套🧤,袖口用胶带扎起来,双手用酒精消好毒。 打开BSC并开灯后,工作台得用酒精擦一遍,所有要进入BSC的物品都得用酒精喷一遍,包括双手。如果手从里面出来又要进去,要再喷一遍,千万别嫌麻烦。如果这些杀菌消毒步骤没做好,细胞马上就能死给你看😵。
② Cell Culture Medium (细胞培养基)
比较常见的培养基有如DMEM,RPMI-1640……不同的细胞对于培养基的要求不一样,比如,我现在有在养的LNCaP细胞就需要RPMI-1640,Du145细胞就需要DMEM;如果用DMEM养LNCaP细胞,LNCaP是长不活的(以前不信邪,传细胞的时候试过😅)。有些细胞甚至比较挑剔,要特定的抗生素,或特定的什么配方。所以呀,养细胞前一定要先查查养的细胞要用什么培养基配方。
我们首先拿到的是Basal Medium (基础培养基,如图),但肯定不能直接拿来养细胞的,培养基要用前要先过滤 (如图),然后加补充物🧪。正常一定要加的是10% FBS (Fetal Bovine Serum, 胎牛血清),有些实验室会加抗生素防止细菌污染🦠,但我们实验室是不加的,这就考验大家的技术了,杀菌工作一定要做好。
配好的培养基可以放在4℃冷藏,要用前放37℃水浴热上。
③ Other Materials (其他材料)
其他要用的试剂包括:Trypsin (Trypsin-EDTA, 0.25%, 胰蛋白酶),PBS (Phosphate Buffered Saline, 磷酸缓冲盐水)
要用的器材包括但不限于:各种tubes,各种culture plates/dishes/flasks,各种pipettes,incubator (37℃, 5% CO2),waste asperting system,water bath,ice……
新的袋装的器材要在BSC里面才能打开,用完用胶带封好才能拿出来,各种瓶瓶罐罐的要用autoclave过的。

Basal Medium

Medium先filter,并加10%FBS

常见养细胞布置如图(我的习惯是这样↑,每个人习惯可能不一样,但sterilize工作一定得做好)
细胞传代 Cell Passaging

这是我正养着的两盘Du145细胞
我一般会写上细胞类型,日期,和细胞的用途(keep,for transfection, for freezing, new-thaw…)
细胞传代是养细胞的关键步骤,一般一盘细胞长到70-90%传下一代。所以养细胞时要每天都要看看细胞的状态🔬,太满或太久没换培养基的话细胞就死翘翘了,而且每天观察一下也能确保细胞没被contaminate。我现在养的细胞都是贴壁长的,如果哪天看到全浮在培养基里,那就是挂了😂
标准的cell passaging过程如下:首先先用细玻璃吸管吸走旧的培养液,接着缓慢地加PBS轻轻地洗一遍细胞。吸走PBS后加一两毫升的trypsin,放回incubator里等个三分钟⏱️,这个过程是让trypsin消化蛋白让细胞从盘上脱落。细胞脱落后往里加入一定量的培养基停止酶的反应(我习惯是加到十毫升),给它混匀并吸出到离心管里。然后1000 rpm 离心个三分钟,让细胞分离出来。吸走上清液后,用新鲜培养基重新混匀细胞。接着就是按你想要的比例种到盘里了,如果长得快的细胞可能传少点,稀释1:10甚至0.5:10;长得慢的可能多传点,二传十或者更高;这个步骤取决于不同细胞,还取决于你的实验安排,哪时候要细胞,要长快点还是慢点。。。种好细胞给它晃匀后放incubator等它长就行了。
我自己的做法呢,肯定很不标准啦😅(bushi。每个人习惯不一样,做法当然不同了。比如说吸走旧的培养基之后我经常不用PBS洗,直接加trypsin让它脱落,这也不是不行,就是得在incubator放久点或者trypsin量多点。对于一些特定的细胞系,像293T,Hela,或者DuNE,其实不用加trypsin,洗一下就掉,我也会跳过加trypsin的步骤直接离心。不过如果太久没用trypsin的话也会出问题的,细胞最后会结块,影响后续的实验。每个人的习惯也许不一样,但总的来说,传细胞不但要把手练熟了,也要对细胞的生长态势做好判断,让细胞长得符合你预期的效果是最好的。毕竟是我们在养细胞,而不是细胞在养我们😁
细胞冻存及解冻 Cell Freezing and Thawing
养细胞还有一个重要的步骤就是冻存和解冻细胞。不断冻细胞一来可以备份,防止现在养的细胞contaminate或挂掉💀;二来可以保证做实验细胞代数的稳定,不至于细胞养得老化掉,细胞性质都变了。
细胞一般冻存在-80℃或液氮里🥶,-80℃里还不够稳定,可以放个一两年;液氮里就几乎可以永远存着了。冻存细胞要配专门的freezing medium,📜配方为:40%养该细胞所用的medium + 50% FBS + 10% DMSO。
细胞冻存的具体步骤如下,首先先收细胞,并离心出cell pellet出来,然后用freezing medium打散,分装到冻存管(cryovial)里🧪,把冻存管装到freezing contianer里放到-80℃就ok了。如果要放液氮里,要先在-80℃放一晚,第二天再放液氮里,记得做好decumentation📝,记好是放在液氮罐的哪个位置。一般一盘满细胞的10cm盘可以冻存成3-4个管,每个管1.5ml;所以我一般的习惯是等一盘长满,离心之后加4.5ml freezing medium打散,然后分到三个管里,每个管都标好cell line,冻存时间,代数,特殊的修饰或treatment之类的。

图为我正要冻存的细胞
冻存细胞比较简单,反正丢冰箱里就冻上了,但解冻就得小心了,因为动作得快,一不留神整管细胞就死翘翘了😵💫。首先你得把BSC里要用的实验器材都给准备好,然后再去-80℃或液氮里把细胞拿出来(玩液氮的时候记得做好防护)。细胞拿来之后就马上放到37℃水浴里(用架子,注意管口别沾水),放一到两分钟!放一到两分钟!放一到两分钟!重要的事情说三遍😂。
在37℃里一到两分钟管里的冰就刚好融化,然后马上加medium然后centrifuge。细胞要刚刚好融化,甚至不用完全化开,中间有一小块冰也没事,直接倒离心管里加medium离心;但一定不能全融化了又放很久,这样整管细胞就死了!因为freezing medium里有10%的DMSO,还又加热,对细胞毒性挺大的😵。加完medium并centrifuge完后,把旧的medium吸掉,然后加新鲜的medium打散加到盘里就行了。一般刚解冻的细胞要先传一代才能做实验,因为这时候细胞状态不太好,实验结果自然不行,所以如图一般刚解冻的我会标上new-thaw,然后解冻完第二天换一次medium。
数细胞 Cell Counting
有些实验必须定量细胞的浓度,这时候就得数细胞🔢。我们实验室是用cell counter数的,用10µl的细胞与10µl Trypan blue混合然后加到counting slide里,有两个chamber,每个加10µl,然后插到cell counter就能自动数出来活细胞的浓度了。数出来两次结果取平均,如果结果差得太远那得多数几次。
有的实验室是用hemocytometer (血细胞计数板) 数的,这时候就得在显微镜下自己手动数每格多少活细胞,然后算出细胞浓度。
其他注意事项 Other Precautions
- Cell incubator得保持37℃,5%CO2,所以二氧化碳罐用完要及时更换,以保证二氧化碳的供应。Incubator里也得保持湿度和无菌,所以一旦湿度不足,AquaClean溶液(5ml AquaClean + 1L 水)要及时加到底下的盘里(有些实验室用的硫酸铜或其他溶液)。
- 装废液的锥形瓶不能太满,太满容易通过吸废液的管道contaminate细胞。所有吸走的废液要加bleach充分灭菌后才能倒掉。不要的细胞也要加bleach静置半小时以上才能倒掉丢弃。
- 一旦发现contamination,要及时把细胞丢掉,然后消毒BSC和incubator。
- 每次传细胞做好记录,方便追溯细胞的代数,以确保细胞的性质大体不变。
养细胞的大致步骤就是这样吧,如果还有什么想起来的要点我就加在其他注意事项里。养细胞也不是什么玄学,养不活肯定是有哪个步骤让细胞不高兴了😂,多多留意每一步操作就是。作为细胞和分子生物学所有实验的基石,养细胞自然是重中之重的,必须熟练掌握的🤠~